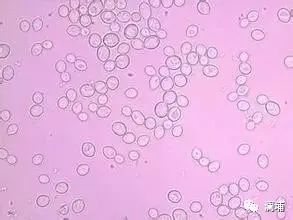
知识篇|啤酒原料酵母 知识篇|啤酒原料酵母
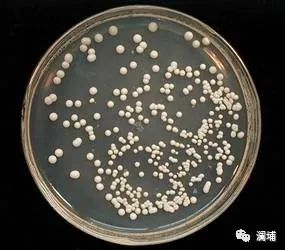
知识篇|啤酒原料酵母 知识篇|啤酒原料酵母

啤酒小精灵

啤酒酵母属于酵母属,在酸性的含糖水溶液(麦汁)中,通过外部的细胞膜(质膜),它们会吸收溶解的糖、简单的含氮物质(氨基酸和非常小的分子肽)、维生素、离子等物质,然后它们通过代谢途径利用这些物质,用于自身的生长和发酵,同时产生丰富的啤酒风味物质。因此酵母是啤酒发酵的主导者,是啤酒酿造的基因,酵母的类别和质量决定着啤酒的种类和风味。
一、啤酒酵母的形态特征
个体形态:啤酒酵母形态一般呈圆形、卵形或椭圆形。
菌落形态:在麦汁琼脂固体培养基上,啤酒酵母呈乳白色的菌落,表面光滑、边缘较整齐,随着培养时间的延长,菌落逐渐变成微黄褐色。
二、啤酒酵母的繁殖方式

啤酒酵母的繁殖方式有无性繁殖和有性繁殖。在正常情况下,啤酒酵母营养体细胞的繁殖方式以无性繁殖的出芽繁殖为主。啤酒酵母生长到一定程度时,在母细胞表面形成一个小突起,母细胞核分裂成两个,其中一个进入小突起内,称为子细胞;当子细胞长到1/2~2/3母细胞大小时,子细胞自动脱离母细胞,形成一个独立的细胞。

啤酒酵母的繁殖和生长可划分为六个不同阶段:
1、调整期:此阶段也称为起始阶段,是进行新陈代谢的活化过程。此阶段的时间长短波动很大,主要取决于有机体类型、培养代数、培养条件等因素。细胞一旦开始分离就标志着此阶段结束。
2、加速期:此阶段紧接调整期,细胞分离速度加快。
3、对数增长期:在此阶段,细胞呈对数增殖,增殖速度最大且保持恒定。此时形成新的一代所需时间最短(即细胞数翻倍的时间)。在最佳增殖条件下世代时间为90~120min。
4、减速期:由于各种因素,比如底物减少,抑制生长的代谢物增加等,对数增长阶段有一定的时间限制,随后进入增殖速度逐渐减小的减速期。
5、稳定期:这一阶段微生物的数量保持恒定。
形成的新细胞数与死亡的细胞数相等。
6、死亡期:在此阶段,细胞死亡数多于形成的新细胞数,细胞数减少。
三、啤酒酵母的分类

上面酵母:①它是啤酒酵母的原始菌种。②可形成芽簇,在旺盛发酵时上升并进入发酵液的泡盖中,其凝聚沉淀性较差。③能形成孢子,可发酵1/3的棉子糖,不能发酵蜜二糖。④发酵温度在15~25℃,常用20~25℃,对低温很敏感。⑤产生特有的酯香味。⑥啤酒的发酵度较高。

下面酵母:①不易形成芽簇,子、母细胞很快分离,主发酵结束时,酵母沉降于容器底部,其凝聚沉淀性较强。②不易形成孢子,能全部发酵棉子糖和蜜二糖。③发酵温度为5~12℃,常用9~12℃,对低温能较好的适应。④可进行酵母洗涤,但一般大罐发酵工艺很少回收后进行酵母洗涤。
四、啤酒酵母的代谢途径

酵母接种后,开始在麦汁充氧的条件下,恢复其生理活性,以麦汁中的氨基酸为主要的氮源,可发酵糖为主要的碳源,进行呼吸作用,并从中获取能量而发生繁殖,同时产生一系列的代谢副产物,此后便在无氧的条件下进行酒精发酵。
发酵副产物的形成和分解:
生青味物质:双乙酰、醛、硫化物,使啤酒口味不纯正、不成熟、不协调。
芳香物质:高级醇、酯,决定啤酒的香味。
以上主、副产物的数量与性质决定了啤酒的质量。它们影响啤酒质量的方面有:
(1)口味:双乙酰含量高了有馊饭味,乙醛含量高了有生青味,高级醇含量高了有异臭味等。
(2)泡沫:CO2含量高则相应的泡沫要多些。
(3)香味:酯类物质含量高会带来不同的酯香味。
(4)稳定性:包括风味稳定性、生物稳定性和非生物稳定性等方面。
五、啤酒酵母的扩大培养

啤酒酵母扩大培养是指从斜面种子到生产所用的种子的培养过程。酵母扩培的目的是及时向生产中提供足够量的优良、强壮的酵母菌种,以保证正常生产的进行和获得良好的啤酒质量。一般把酵母扩大培养过程分为二个阶段:实验室扩大培养阶段(由斜面试管逐步扩大到卡氏罐菌种)和生产现场扩大培养阶段(由卡氏罐逐步扩大到酵母繁殖罐中的零代酵母)。扩培过程中要求严格无菌操作,避免污染杂菌,接种量要适当。
1、出发菌株的分离(出发菌株即用来扩大培养的起始菌株)
平板分离培养法
划线分离法
2、实验室扩大培养
斜面试管→富氏瓶或试管培养→巴氏瓶或三角瓶培养→卡氏罐培养
3、生产现场扩大培养
汉生罐→一级繁殖罐→二级繁殖罐→发酵罐


微信号|zw-lab
